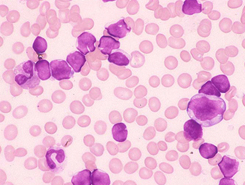

症例17 成人例です。
末梢血、骨髄所見から表現型と考えられる病態は何でしょうか。 解説と解答
WBC 41,200/μl, RBC310万/μl, Hb 11.2g/dl, Ht 27.4%, PLT 8.4万/μl, MCV 88.3fl,
MCH 36.1pg, MCHC 40.8%, NCC: 14.6万/μl, MgK 0/μl, 鼠径部・頚部リンパ節腫大
![]() |
![]() |
|
|---|---|---|
| [PB-MG.x1000] |
[BM-MG.x400] |
|
![]() |
![]() |
|
| [BM-MG.x1000] |
[LN-HE.x200] |
|
【症例17.の選択肢】
| A. 【 主な表現型・遺伝子 】 | |
| 1 | CD5・CD19・CD20・CD23・ sIg陽性 |
|---|---|
| 2 | CD5陰性, CD10・CD19,・CD20・sIg陽性 |
| 3 | t(14;18)(q32;q21)/BCL2陽性 |
| 4 | CD5陽性, CD10陰性, cyclinD1陽性 |
| 5 | t(8;14)(q24;q32)/ IgH陽性 |
| B. 【 考えられる病態 】 | |
| 1 | 慢性リンパ性白血病 |
|---|---|
| 2 | 前リンパ球性白血病 |
| 3 | ろ胞性リンパ腫 |
| 4 | リンパ形質細胞性リンパ腫 |
| 5 | ヘアリー細胞白血病 |
【ねらいと解説】
成人例です。白血球増加と貧血、リンパ節腫大がみられました。
末梢血では小型〜中型(10〜16μm)で、N/C比が高いリンパ球が60%みられ、なかには核形
不整の細胞がみられました。正形成の骨髄にはリンパ球は75%みられ、一部には核中心性
へ幅の狭い切れ込みを有する特徴的な細胞がみられました。
リンパ節生検のHE染色ではろ胞様構造がみられました。
ろ胞構造は反応性にもみられますが
腫瘍性では大小不同に乏しく均一で細胞が増生し丸い傾向にあるようです。本例のHE染色の像を目を近づけたり離したりしてよく観察しますと均一の増生と円形のろ胞
構造を認めるため腫瘍性がうかがえそうです。特徴的な核形不整とろ胞構造よりろ胞性リンパ腫
が考えられます。組織像ではろ胞性とび慢性領域の混在があるため、それらの鑑別には面積比が有効とされ、ろ胞形成が75%以上占めるようであればろ胞性を強調でき、25〜75%はろ胞性とび慢性の混在が考えられるようです。表現型では、CD10、CD19、CD20、sIgが陽性であり、t(14;18)(q32;q21)/BCL2
を認めたため、ろ胞性リンパ腫と診断されました。
【解答】
A-2. CD5(−), CD10, CD19, CD20, sIg陽性 3. t(14;18)(q32;q21)/BCL2陽性
B-3. ろ胞性リンパ腫
【正解率】
A. 20%
B. 100%